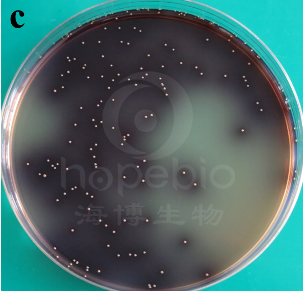

海博微信公众号
海博微信公众号
 海博天猫旗舰店
海博天猫旗舰店


 海博微信公众号
海博微信公众号
 海博天猫旗舰店
海博天猫旗舰店




粪肠球菌(Enterococcus faecalis)原名粪链球菌,但由于与其他链球菌差异较大,基因序列同源性低,因此与屎肠球菌同时从链球菌属分离出来,成立肠球菌属。粪肠球菌能产乳酸,通常不易造成感染,但部分菌株携带独立基因,且耐药性较强,感染后较难治疗。
一、粪肠球菌的选择性增菌培养
若样品中粪肠球菌含量不占优势,可先进行选择性增菌培养,通常使用肠球菌肉汤或叠氮钠葡萄糖肉汤。
二、分离培养
分离粪肠球菌的传统培养基通常有两类:一类是胆汁-七叶苷琼脂,由于粪肠球菌对胆汁有较强的耐受性,且能分解七叶苷,在肠球菌琼脂上菌落呈黑色,菌落周围变为棕黑色(分解七叶苷与铁离子反应变黑),一类是利用粪肠球菌对TTC有较强的耐受性,使用KF链球菌琼脂/Slanetz和Bartley培养基,培养基中含有较高浓度的TTC及叠氮钠,粪肠球菌可在此培养基中生长并还原TTC,菌落呈深红色。但由于屎肠球菌及部分其他肠球菌属存在同样的特性,因此在这些培养基上菌落形态较为相似,需进一步鉴定区分。
|
 |
|
肠球菌琼脂-粪肠球菌 |
KF琼脂-粪肠球菌 |
三、粪肠球菌的鉴定(参考GB8538标准)
1、革兰氏染色:粪肠球菌为革兰氏阳性球菌,通常为链状或成对排列。
2、触酶试验:挑取菌落至3%过氧化氢中,粪肠球菌触酶试验为阴性,不产生气泡。
3、45℃生长试验:粪肠球菌具有一定的耐热性,挑取菌落转接至BHI培养基中,45℃培养至48h,应明显浑浊生长。
4.胆汁耐受试验:粪肠球菌对胆汁具有较强的耐受性,挑取菌落转接至胆汁液态培养基中36±1℃培养至3天,应明显浑浊生长。
注:本文属海博生物原创,未经允许不得转载。
上一篇:大肠菌群培养基检测方法详解
下一篇:肠球菌的活化与保存
| 相关文章: | |



